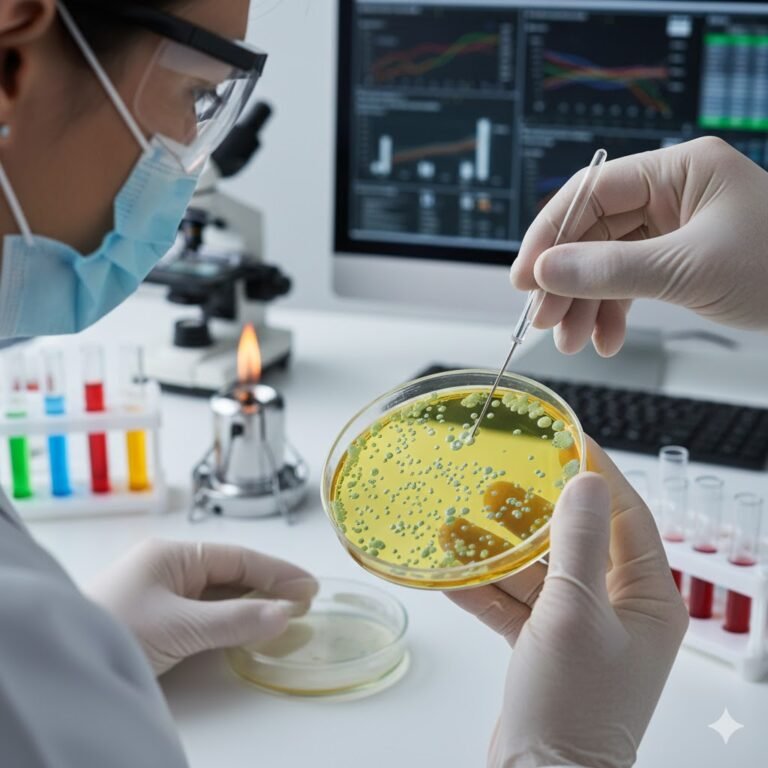
Urine Culture in Std Testing Dubai

STD Testing Dubai at Home
Residents and visitors in Dubai can now access 100% confidential STD testing from home. Provided by DHA-licensed services like Al Hosna At Home, a professional nurse visits your location for sample collection. Results are typically delivered via secure digital portals within 24 hours, ensuring privacy and convenience without a clinic visit.